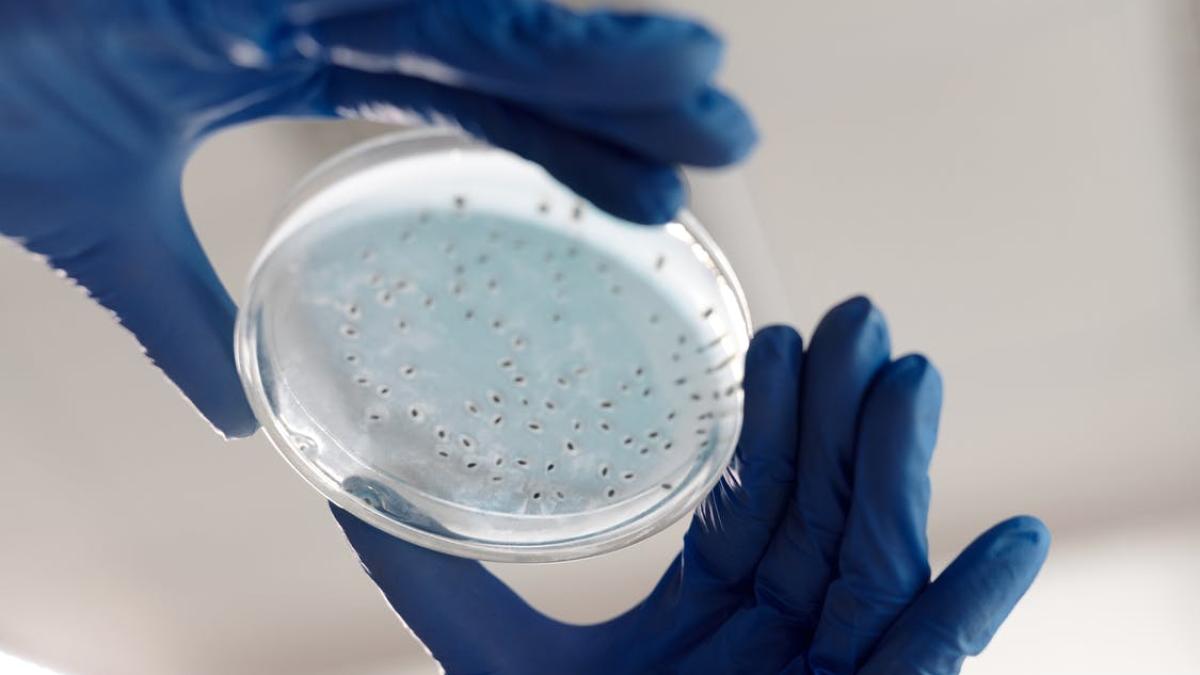
pexels-photo-4031501_07942100

Luni, producătorul italian de dulciuri Ferrero a retras de la comercializare ouăle de ciocolată Kinder Surprise în Marea Britanie şi Irlanda, precizând că este vorba de o măsură preventivă. Miercuri, Ferrero a revenit şi a spus că niciun produs marca Kinder comercializat pe piaţă nu a ieşit pozitiv atunci când a fost testat pentru salmonella.
Într-un comunicat de presă publicat miercuri, ECDC şi EFSA nu au menţionat numele Ferrero sau al oricărei alte companii dar au atras atenţia că la data de 5 aprilie au fost raportate 134 de cazuri de infecţie cu salmonella, în principal în rândul copiilor cu vârsta de până la 10 ani.
"Această epidemie se caracterizează printr-o proporţie neobişnuit de mare de copii spitalizaţi, unii cu simptome severe precum diaree cu sânge", a precizat Centrul European pentru Prevenirea şi Controlul Bolilor.
Conform datelor publicate miercuri, Marea Britanie are cel mai ridicat număr de incidente, cu 63 de cazuri de infecţie cu salmonella confirmate până la data de 5 aprilie. Alte state cu cazuri confirmate sau probabile sunt: Franţa, Irlanda, Belgia, Germania, Luxemburg, Ţările de Jos, Suedia şi Norvegia.
"Fiul secret" al prințului Charles împărtășește "noi dovezi" că este copilul lui
ECDC a precizat că retrageri de produse de la raft au fost lansate în mai multe ţări, inclusiv Belgia, Franţa, Germania, Irlanda, Luxemburg şi Marea Britanie.
Separat, grupul Ferrero a informat marţi că a decis să retragă de la comercializare o serie de produse Kinder fabricate la uzina sa de la Arlon (Belgia) şi care erau vândute în Franţa, Belgia, Marea Britanie, Irlanda de Nord, Germania şi Suedia.
Toxiinfecţiile alimentare provocate de salmonella se manifestă prin tulburări gastrointestinale însoţite deseori de febră în primele 48 de ore de la consum.